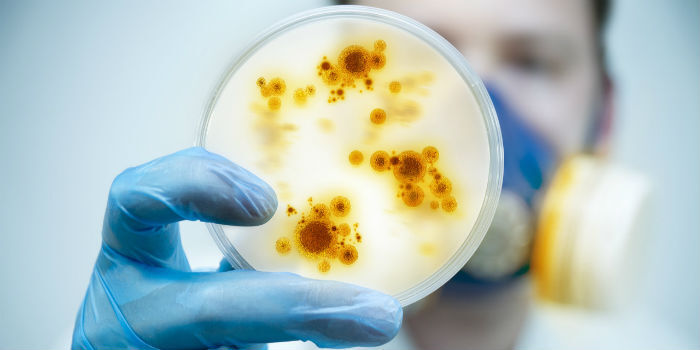
香港暂无确诊新型冠状病毒肺炎病例，118例疑似病例88例已出院

新型肺炎疫情地图更新:四川省再确诊1例 重庆市确诊5例
与四川紧邻的重庆市,亦在1月21日晚间,确诊5例输入性新型冠状病毒感染的肺炎病例。 截至目前,除按要求首例病例需国家卫生健康委确认外,按照《新型冠状病毒感染的肺炎诊疗方案》(试行第二版),经重庆市市…
工信部再补充说明新能源汽车补贴问题:政策详情待定但会平缓退坡
针对这一企业普遍关注的问题,工业和信息化部部长苗圩在会上作了回应,为稳定市场预期,保障产业健康持续发展,今年的新能源汽车补贴政策将保持相对稳定,不会大幅退坡,希望行业企业坚定发展信心,加大创新力度,提升产品品…
我得新型肺炎了吗?怎么治?请收好这份官方防护指南
一旦出现了发热或者咳嗽症状时,焦雅辉建议一定要戴口罩:“我们提倡口罩文明,打喷嚏要用手绢或者纸捂住口鼻。 焦雅辉提示道,在目前的季节,正处于其他呼吸道疾病高发的季节,抵达医院后,在排除其他呼吸道疾病…
香港暂无确诊新型冠状病毒肺炎病例,118例疑似病例88例已出院
官网信息显示,1月20日中午至1月21日中午香港卫生署卫生防护中心收到呈报12宗怀疑个案。 1月20日中午之前呈报仍在住院的个案中,有9宗被确诊为感染其他类型病毒(包括不限于胰病毒、人类鼻病毒/肠病…
中国疾控中心公开回应2000人感染一说:“事实是事实,知识理论是理论”
经济观察网 记者 王雅洁 对于英国相关学校研究预估有2000人在中国受到新型冠状病毒感染一事,中国科学院院士、中国疾病预防控制中心主任高福给出正面回应。这样的模型是不是和事实相符合,刚才李主任已经把我们…
有数据瞒报吗?会演变成另一场SARS吗?人传人之后咋办?国家卫健委直面三大焦点问题
为使社会公众及时、准确、全面掌握疫情的信息,从1月20日起,国家卫生健康委员会每日汇总发布全国各省份确诊病例和疑似病例数据,大家在国家卫生健康委员会的网站可以看到。当然,就像刚才高福院士提到的,我们对这个疾病…
新型冠状病毒疫情搅动A股 口罩概念股走势分化 这两家公司结束两连板行情
随着武汉、北京、广东、上海、浙江等地接连发布新型冠状病毒肺炎疫情,医药制造、医疗行业上市公司在1月20日、21日全线启动,部分上市公司在21日晚间发布股票交易异常波动的公告,对相关情况进行了说明。 …
一位带娃在外晃荡的母亲进退两难:武汉应更早让公众重视
言咏/文 当卫健委高级别专家组组长钟南山1月20日告诉公众,起源于武汉的新型冠状病毒肺炎存在“人传人”现象时,我正带着孩子在长隆度假区的一家酒店里。 公众是从钟南山口中得知武汉有14名医护人员被感染…
剑指武汉!国家卫健委要求”严防死守” 把疫情控制在武汉
把好“出口关”,落实机场、火车站、汽车站、码头等体温筛查,严格采取发热患者和密切接触者隔离观察措施,最大程度减少公众聚集性活动。 在患者救治上,相关部门将调配最强的中西医疗资源和专家资源,中西医结合,最大…
广东省新增3例新型冠状病毒肺炎确诊病例,3例均有湖北居住史或旅行史
经济观察网 记者 刘可广东省卫健委消息,截至今日(1月21日)晚6时,广东省新增3例新型冠状病毒感染的肺炎确诊病例。现广东省累计发现确诊病例17例,其中重症5例,危重2例,无死亡病例,另有4例疑似病例正…